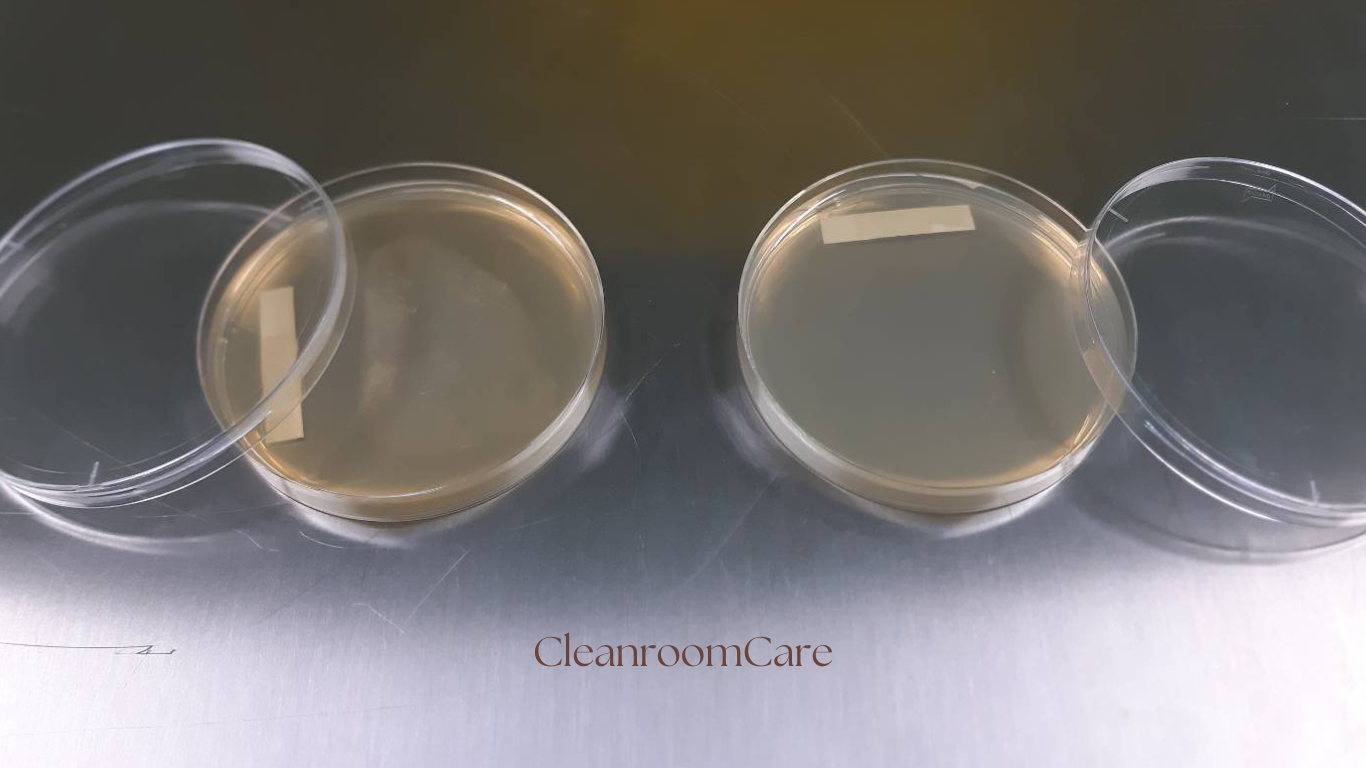

About us
We are the leader of Laundry service for factory. Now we are expanding our business for Clean room Non-Stop-Service to support customer in industrial area.
We support service for “Smock suit Laundry & Equipment Laundry ” , we have Clean room for washing its product under international standard by control contamination & ESD.
คลีนรูมแคร์ คือผู้นำด้านนวัตกรรมการทำความสะอาดระดับโมเลกุล ให้แก่ลูกค้ากลุ่มอุตสาหกรรม
ที่ต้องการความสะอาดสูง มาอย่างยาวนาน ในกลุ่มลูกค้า อิเล็กทรอนิกส์ ฮาร์ดดิสก์ อาหาร และยา โดยมุ่งเน้นให้เป็นไปตาม Cleanroom Standard ในแต่ละขั้นตอน ทั้งการเลือกใช้น้ำยาที่ถูกต้อง การวัดฝุ่นในระดับเล็กถึง 0.1ไมครอน
และค่าESD ที่อาจจะกระทบต่อผลิตภัณฑ์ของลูกค้าได้ เราจึงใส่ใจในรายละเอียด และการรายงานผล ที่ถูกต้องแม่นยำ
โดย Lab ที่ได้มาตรฐาน ISO 17025
Our 4 service modules for your Cleanroom
Cleanroom Garment Laundry
Big Cleaning for Cleanroom
Cleanroom Products
Cleanroom Technical service or
Laboratory tests
Our Service
Our 4 service modules for your Cleanroom

CONTACT US
working time: 8:00 - 17:30
After work please contact 094-002 5549 คณนุ้ย
083-814 8079 คุณลัดดา (24hr. on service)
094-002 5549 083-814 8079 สำนักงาน 02-035 7187 Fax :02-804 3344
www.cleanroomcare.com
Cleanroom Service Business
Nonthaburi, Pathum Thani (Sale office)
Laundry Branch :Bangkae Bangkok ,Nakornratchasrima
sale@cleanroomcare.com (Sales&marketing)
info@cleanroomcare.com (Support)